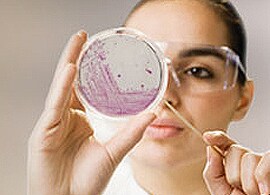
Prepared Culture Media Prepared Culture Media

Search
Search
Whether you are making 100mL or 100L, the same steps apply to media preparation. Eliminate many of these, from weighing out and autoclaving, to tempering, pouring or dispensing using ready-prepared media and convenience formats. Let us help you save time and labor.
Prepared bottled media is used in both clinical and industrial microbiology settings. Browse our complete selection right here to find a wide variety of fill volumes, bottle sizes, caps, and containers to suit your need.
Media fills play a critical role in validating aseptic manufacturing processes. Reduce the burden of media fills with ready-to-use culture media in BioProcess containers with plug and play connectors for easy integration.
Detect microbial contamination or determine bacterial counts in clinical specimens with easy-to-use, easy-to-read dip slides. Make colony counting easier when lab facilities are limited, and decrease the time between collection and inoculation to increase recovery and accuracy.
Detect, presumptively identify, and screen samples for pathogenic and non-pathogenic organisms with speed and accuracy using chromogenic media. Colourful, easy-to-read colonies and short incubation times enable timely and important decision-making for both clinical and food testing laboratories.
When conditions call for a tube, we've got it. When delicate aerobic or anaerobic conditions are called for or when you're looking to isolate and study a specific reaction, a tube of one of the world's favorite brands of prepared media is right here ready for you.
Isolate, identify, differentiate, and perform susceptibility testing on plated media from the experts in microbiological media. With thousands of quality assured formulations and formats available, you're sure to find what you're looking for whether it's routine, specialty, or a custom blend somewhere in between.
Whether you're processing clinical, environmental or manufacturing samples, it's always best to learn as much as you can as quickly as you can. That's why we bring together some of the most widely used, high-performing culture media formulations and put them on a single plate. Our goal is to help you do more, learn more and grow more with less.
Have confidence in your cleanroom or isolator by minimizing risk with our contact and settle plates. With a variety of formulations to choose from, in both irradiated and non-irradiated formats, finding what you need to monitor and control your environment can begin right here.
Do you need to be more efficient and increase the productivity in your routine lab while reducing costs? Watch now to find out how Thermo Scientific™ Bi-plates can help address these challenges.
Have confidence in solutions that bring together the best in food quality and safety testing, and help you remain adaptive, responsive and competitive.
Identify infections and antimicrobial susceptibility quickly and accurately to guide optimal patient care with powerful manual and automated technologies, and a comprehensive line of media.